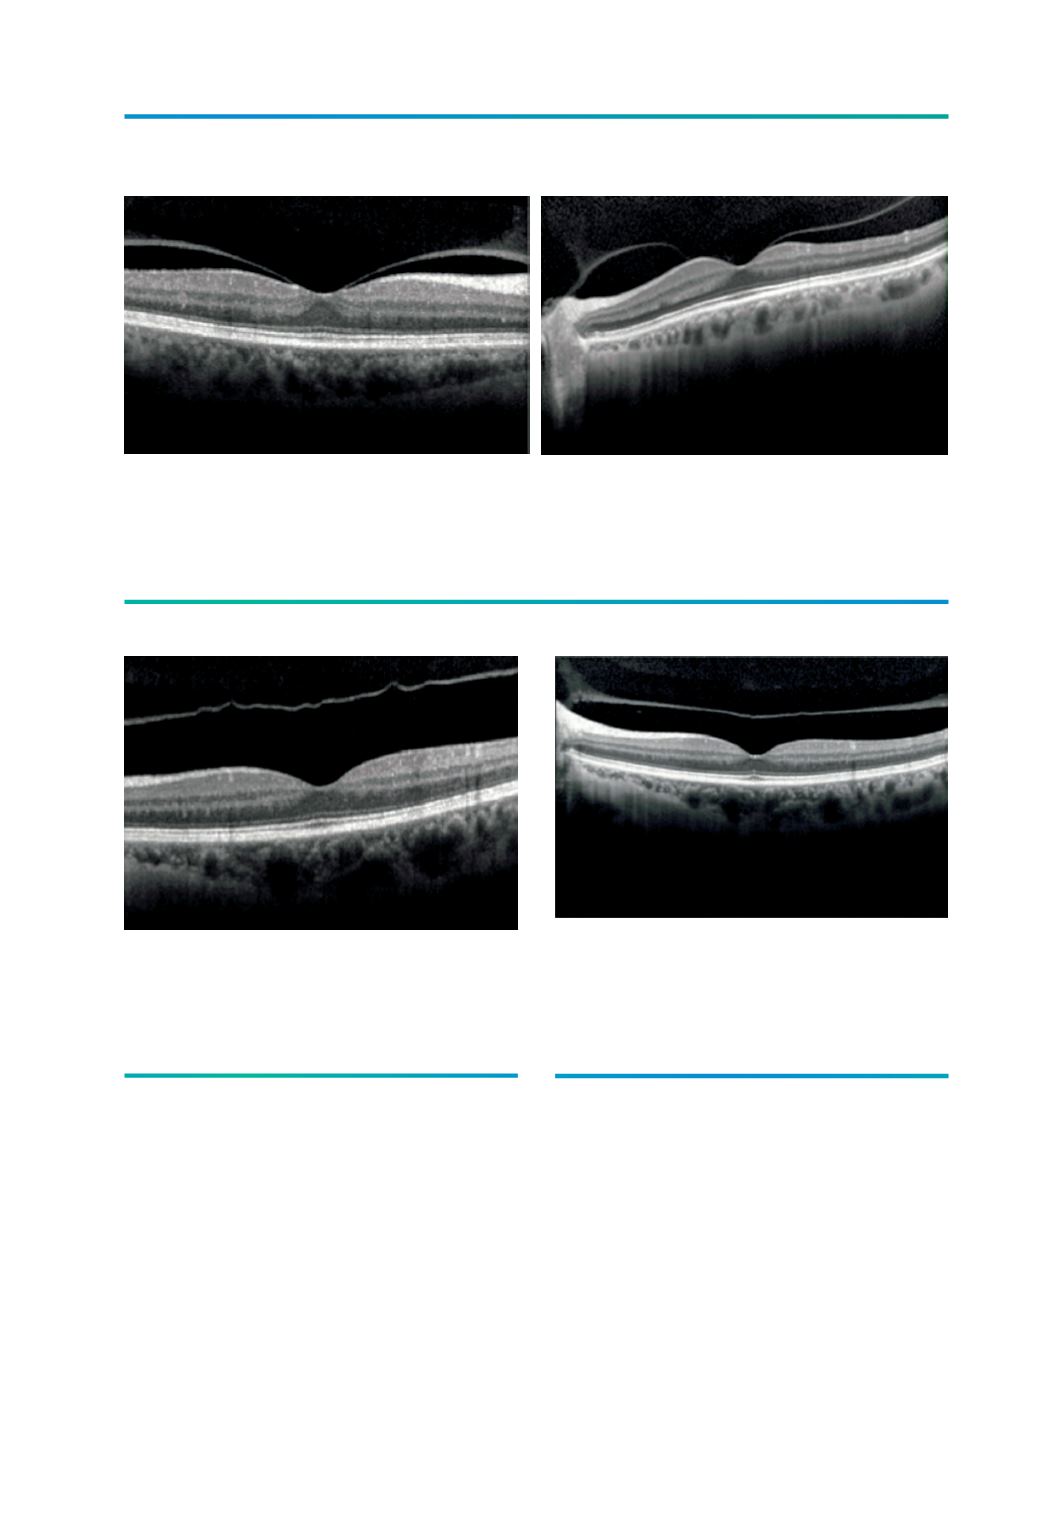
Page Background

17
Capítulo 3. Como se processa o descolamento posterior do vítreo?
O DPV é um fenómeno benigno na maioria
dos casos, devendo, no entanto, salientar-
-se que no Estadio 1 (perifoveal) estão en-
volvidas forças de tracção particulares que
poderão estar na génese de patologia em
casos particulares. Estas forças de trac-
ção são de dois tipos: 1. forças de tracção
estática, com o vector dirigido anterior-
mente e em que a elasticidade da hialóide
posterior força a fóvea anteriormente; e 2.
forças de tracção dinâmica, associada ao
movimento do vítreo liquefeito na sequên-
cia dos movimentos sacádicos dos olhos,
são forças que habitualmente estão distri-
buídas de forma uniforme na retina pos-
terior mas que nesta altura estão concen-
tradas na região foveolar
5
. Estas forças de
tracção contínuas sobre a região macular
podem, na sequência da contracção do ví-
treo, desempenhar um papel importante na
génese do “stress” macular.
Outro aspecto que ajudará a compreender
a patologia vítreo-macular na sequência de
Figura 4.
Imagem de tomografia de coerência óptica de
doente do sexo feminino de 60 anos mostrando a
separação vítreo-macular completa (Estadio 2).
Figura 3.
A) Imagem de tomografia de coerência óptica de doente do sexo feminino de 75 anos mostrando a
separação do vítreo-perifoveal com adesão vítreo-foveolar residual (Estadio 1); B) Imagem de tomografia de
coerência óptica de doente do sexo feminino de 72 anos mostrando a separação do vítreo-perifoveal com
adesão vítreo-foveolar e ao nervo óptico (Estadio 1).
Figura 5.
Imagem de tomografia de coerência óptica de
doente do sexo feminino de 60 anos mostrando a
separação incompleta do vítreo, ainda aderente ao
bordo do nervo óptico (Estadio 3).
A
B


















